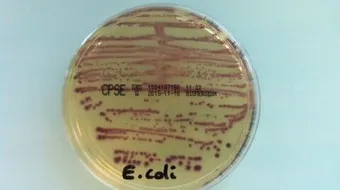
تحليل مزرعة البول

تحليل مزرعة البول
تحليل مزرعة البوليُعدّ تحليل مزرعة البول أو زراعة البول (بالإنجليزية: Urine culture) أحد التحاليل المخبريّة التي تساعد على الكشف عن الإصابة بأحد أشكال العدوى

تحليل مزرعة البول
يُعدّ تحليل مزرعة البول أو زراعة البول (بالإنجليزية: Urine culture) أحد التحاليل المخبريّة التي تساعد على الكشف عن الإصابة بأحد أشكال العدوى المختلفة في الجهاز البوليّ، وفي معظم الحالات يتمّ جمع عيّنة البول داخل عبوةٍ خاصةٍ، أو قد تحتاج بعض الحالات إدخال القسطرة البولية وصولاً إلى المثانة للحصول على عيّنة البول، كما تجدر الإشارة إلى أنّ الطبيب قد يُدخل إبرة عبر البطن وصولاً إلى المثانة لسحب عيّنة البول في بعض الحالات النادرة، ويفضّل تجنّب التبوّل لمدّة 2-3 ساعاتٍ تقريباً قبل جمع عيّنة البول.[1]
دواعي إجراء تحليل مزرعة البول
يتمّ إجراء اختبار زراعة البول في العادة في حال الشكّ بالإصابة بعدوى الجهاز البوليّ، أو ظهور بعض الأعراض التي قد تدلّ على الإصابة بالعدوى في الجهاز البوليّ، أو وصولها إلى الكلى، كما قد يتمّ إجراء التحليل للمرأة الحامل في أول زيارة للطبيب، أو خلال الثلث الأول من الحمل حتى لو لم تظهر عليها أيٌّ من أعراض العدوى، للمساعدة على الكشف المبكّر عن وجود بكتيريا في البول لما قد يكون لها من تأثير في صحة الجنين، ومن الجدير بالذكر أنّ تحليل زراعة البول لا يتمّ إجراؤه في جميع حالات عدوى الجهاز البوليّ عادةً، وإنّما في الحالات التي لا تستجيب للعلاج بالمضادّات الحيويّة الموصوفة، أو الحالات المعقّدة فقط.[2]
تفسير نتائج تحليل مزرعة البول
بعد إرسال عيّنة البول إلى المختبر تتمّ زراعتها ضمن بيئة خاصة لعدّة أيّام للسماح للبكتيريا أو أيٍّ من أنواع الكائنات المجهريّة الأخرى بالنمو، وفي حال ظهور عددٍ قليل من الكائنات المجهرية تكون النتيجة سالبة، أمّا في حال ظهور البكتيريا أو أنواع أخرى من الكائنات المجهريّة فتُعتبر النتيجة موجبة، ويمكن من خلال هذا التحليل تحديد نوع البكتيريا المسبّبة للعدوى، إمّا عن طريق مشاهدتها تحت المجهر، وإمّا عن طريق إجراء اختبارٍ إضافي، ويتمّ تحديد العلاج المناسب من قِبل الطبيب بناءً على النتائج الظاهرة.[3]
المراجع
- ↑ "Urine culture", medlineplus.gov, Retrieved 27-1-2019. Edited.
- ↑ "Urine Culture", labtestsonline.org, Retrieved 27-1-2019. Edited.
- ↑ Kimberly Holland, Kathryn Watson, "Urine Culture"، www.healthline.com, Retrieved 27-1-2019. Edited.
المقال السابق: كيف أعود أطفالي على النوم باكراً
المقال التالي: كيفية إخفاء حب الشباب
تحليل مزرعة البول: رأيكم يهمنا
0.0 / 5
0 تقييم
